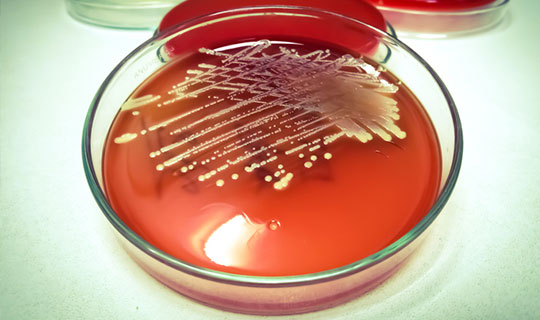

Masako Mizusawa, MD, PhD, MS
Director, Microbiology Center of Excellence, RWJBarnabas Health
Clinical Associate Professor, Department of Pathology and Laboratory Medicine, Rutgers Robert Wood Johnson Medical School
Mohamed Ellethy, MPH, MLS (ASCP)cm, BS
Center of Excellence Microbiology Manager, Monmouth Medical Center
Blood cultures are essential diagnostic tools in pediatrics, helping to identify the specific bacteria or fungi causing bloodstream infections (BSIs). These infections can be life threatening, and timely diagnosis is crucial. Traditional blood culture methods are often able to detect the majority of BSI-causing bacterial organisms within 2–3 days using modern automated systems. This includes even fastidious bacteria like those in the HACEK group (Haemophilus species, Aggregatibacter actinomycetemcomitans, Cardiobacterium hominis, Eikenella corrodens, Kingella kingae) and Brucella. However, some microorganisms, such as Cutibacterium acnesmay take longer to grow or require specialized culture media or techniques. Fungal and mycobacterial blood cultures often need additional processing, like lysis-centrifugation and need separate orders from those for conventional bacterial blood cultures. While most Candida species can be detected using standard blood culture methods, it’s important to note that blood cultures may not always be positive in patients with suspected candidemia.
When to Draw Pediatric Blood Cultures
Blood cultures should be considered in pediatric patients with signs and symptoms suggestive of a BSI. These may include: a fever of 100.4°F (38°C) or higher, hypotension, tachycardia, tachypnea, lethargy, poor feeding or decreased oral intake, meningitis, or sepsis. It is important to note that these symptoms can also be indicative of other conditions, and a thorough clinical evaluation is necessary to determine the need for blood cultures. In most cases, only one set of blood culture is collected for pediatric patients, which makes it challenging to distinguish between blood culture contamination and true bacteremia. Consequently, obtaining unnecessary blood cultures may lead to unnecessary antibiotic use, which could negatively impact patient care.
Volume of Blood for Pediatric Blood Cultures
Higher blood volumes correlate with higher detection rates in blood cultures. The volume of blood drawn should be adjusted based on the child’s weight to maximize diagnostic yield. Below is a table with guideline recommendations for weight-based blood volume for blood cultures in pediatric patients. The blood volume should also be adjusted based on the patient’s clinical condition to ensure safety.
Recommended Volume of Blood for Bulture (mL)

It is important to consult with the laboratory for specific volume recommendations based on the institution’s protocols and the type of blood culture bottles being used.
Criteria for Repeating Blood Cultures
A repeat blood culture for documenting microbiological clearance is generally not indicated if the patient is stable and clinically improving, except in certain cases involving specific organisms (e.g., Staphylococcus aureus and Staphylococcus lugdunensis) or particular situations (e.g., prior to insertion of a permanent vascular catheter).
Key Takeaways
- Blood cultures should be collected early in suspected sepsis cases, ideally before antibiotic administration.
- Use weight-appropriate volumes to maximize diagnostic yield while ensuring safety based on the patient’s clinical conditions.
- Repeat cultures are generally not indicated if the patient is stable and clinically improving, except in certain cases or particular situations.
The ASP, representing pediatric providers, including pediatric infectious disease specialists and pharmacists, exchange ideas, discuss case management strategies and develop and implement guidelines to be shared system wide, as well as serve as a resource for community physicians.
For more educational information, research and best practices from the Children’s Health Network at RWJBarnabas Health, visit rwjbh.org/childrenshealthresearch.
Resources
Garcia-Prats AJ, Cooper TR, Schneider VF, et al. “Effect of Inoculum Volume and Blood Culture Media on Detection of Bacteremia in Children.” Pediatrics. 2000;106(4):660-663.
Simon A, Nadkarni V, Mora Carpio AL. “Blood Cultures in Pediatrics.” StatPearls. Updated September 18, 2023. Available from: https://www.ncbi.nlm.nih.gov/books/NBK470326/
Kuppermann N, Dayan PS, Levine DA, et al. “A Clinical Prediction Rule for Pediatric Patients With Fever and Leukocytosis After Antimicrobial Therapy.” JAMA Pediatr. 2021;175(2):178-185.
Miller JM, Binnicker MJ, Campbell S, et al. A Guide to Utilization of the Microbiology Laboratory for Diagnosis of Infectious Diseases: 2024 Update. Clin Microbiol Rev. 2024;37(1):e00009-23. doi:10.1128/CMR.00009-23